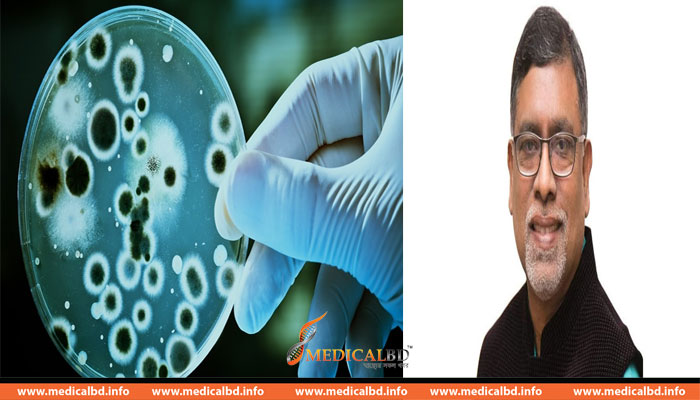

চিকিৎসা বিজ্ঞানের গবেষণার প্রতি গুরুত্বারোপ
স্বাস্থ্য ও পরিবার কল্যাণ মন্ত্রী জাহিদ মালেক দেশে চিকিৎসা বিজ্ঞানের গবেষণায় আরো নজর দিতে বঙ্গবন্ধু শেখ মুজিব মেডিকেল বিশ্ববিদ্যালয়সহ সব চিকিৎসা গবেষণা প্রতিষ্ঠান প্রধানগণকে কর্মপরিকল্পনা প্রণয়নের নির্দেশ দিয়েছেন । গতকাল রোববার সচিবালয়ে মতবিনিময় সভায় সভাপতিত্বকালে প্রধানমন্ত্রী শেখ হাসিনার নির্দেশনার প্রেক্ষিতে স্বাস্থ্যমন্ত্রী এই নির্দেশ দেন। বিএমডিসি (বাংলাদেশ মেডিকেল অ্যান্ড ডেন্টাল কাউন্সিল), বিসিপিএস (বাংলাদেশ কলেজ অব ফিজিশিয়ানস অ্যান্ড সার্জন্স ),
বিএমআরসি (বাংলাদেশ মেডিকেল রিসার্চ কাউন্সিল ), ন্যাশনাল ইনস্টিটিউট অব পপুলেশন, রিসার্চ এন্ড ট্রেনিং (নিপোর্ট), নিপসম (জাতীয় প্রতিষেধক ও সামাজিক চিকিৎসা প্রতিষ্ঠান), নার্সিং এন্ড মিডওয়াইফারি কাউন্সিল-এর প্রধানদের সাথে স্বাস্থ্যমন্ত্রীর এই মতবিনিময় সভার আয়োজন করা হয়। স্বাস্থ্যমন্ত্রী স্বাস্থ্যখাতের ভাবমূর্তি উর্ধ্বে রাখতে স্বচ্ছতার সাথে কাজ করার জন্য সংশ্লিষ্ট সকলকে নির্দেশ দিয়েছেন। তিনি বলেন, জনগণের সেবার গুণগত মান আরো বাড়ানোর লক্ষ্যে কাজে গতিশীলতা আনতে হবে।
এছাড়াও পুরানো কৌশলের সাথে নতুন নতুন আবিস্খারের দিকে বিশেষ নজর দিতে হবে সকলকে। তাছাড়া স্বাস্থ্যমন্ত্রী জাহিদ মালেক হাসপাতালগুলোতে নার্সদের কর্মবন্টন পূর্ণাঙ্গ আকারে প্রস্তুত করতে প্রধানমন্ত্রী শেখ হাসিনার সাম্প্রতিক নির্দেশনা বাস্তবায়নের অগ্রগতি সম্পর্কে উক্ত সভায় জানতে চান। এসময় তিনি দ্রুত নার্সদের কর্মবণ্টন প্রস্তুত করে উপস্থাপনের জন্য নার্সিং অধিদপ্তরের মহাপরিচালককে নির্দেশ দেন। এর পূর্বে স্বাস্থ্য মন্ত্রণালয়ের সভাকক্ষে অনুষ্ঠিত ‘জাতীয় মানসিক স্বাস্থ্য কর্মপরিকল্পনা’ বিষয়ক সভায় স্বাস্থ্যমন্ত্রী সভাপতিত্ব করেন যেখানে সায়মা ওয়াজেদ হোসেন সভায় প্রধান অতিথি হিসাবে উপস্থিত ছিলেন।
medicalbd সাস্থের সকল খবর।
